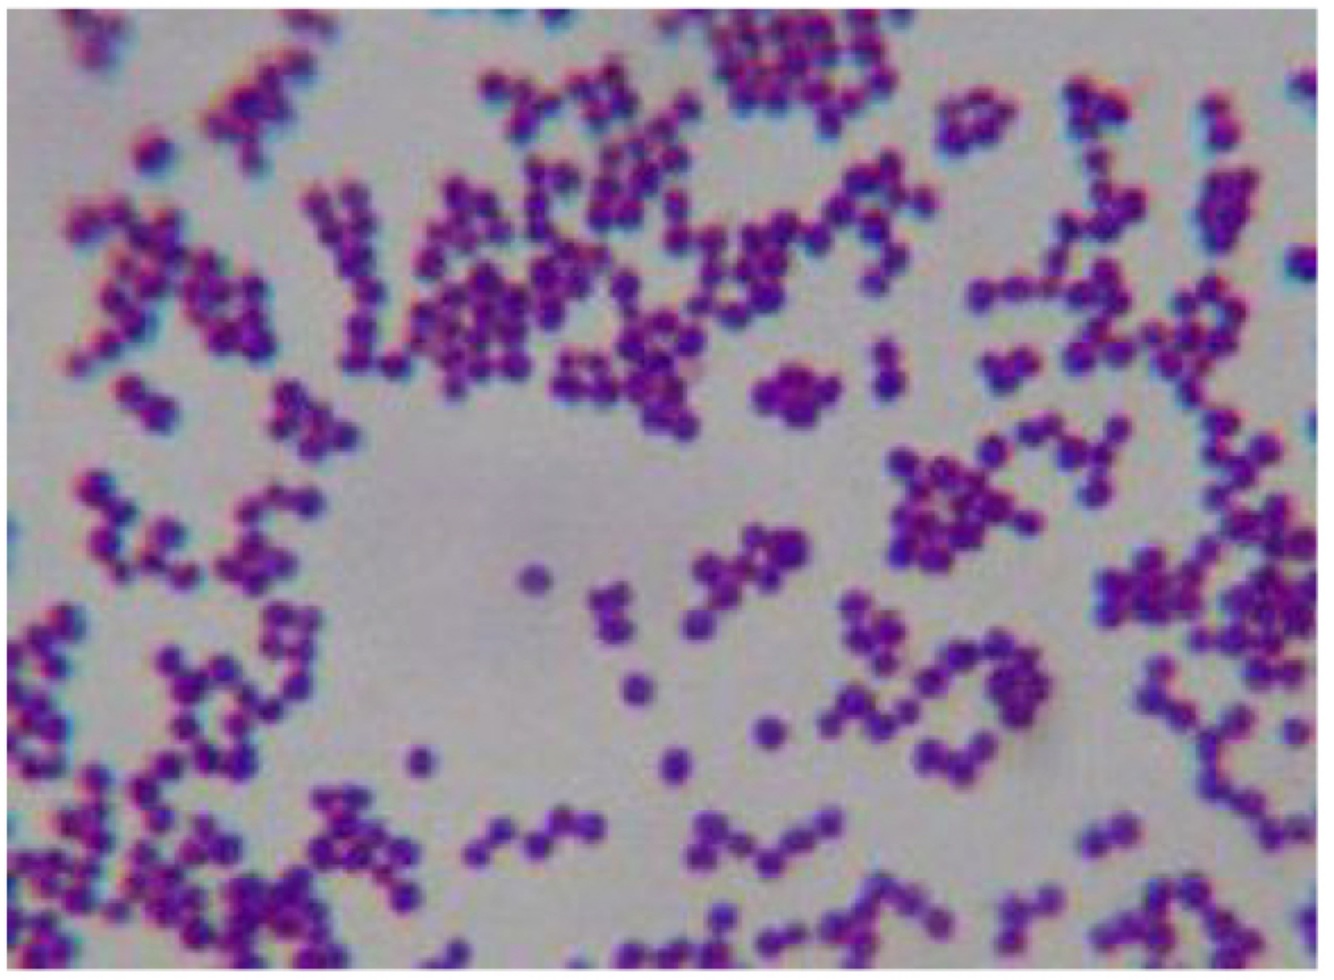
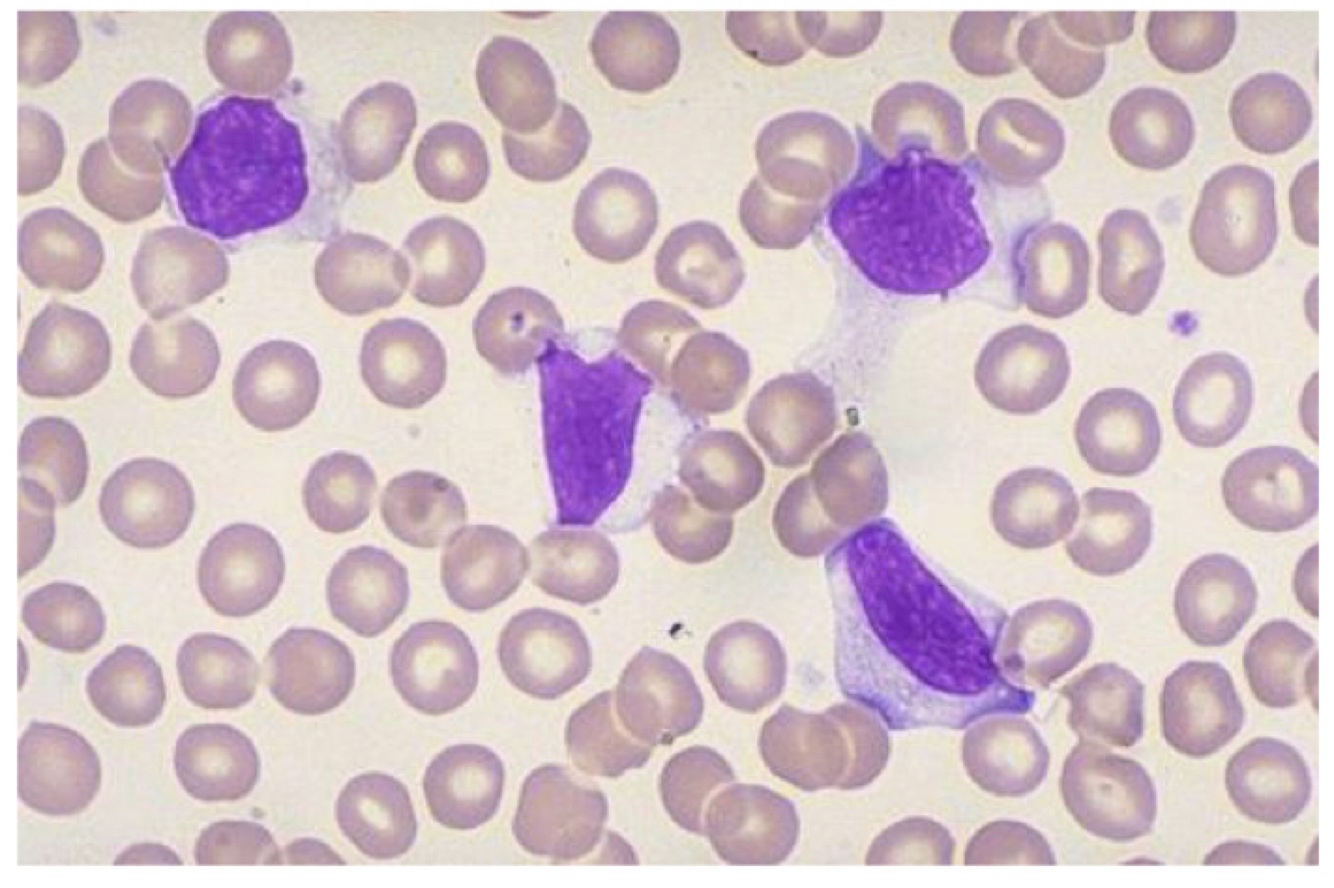
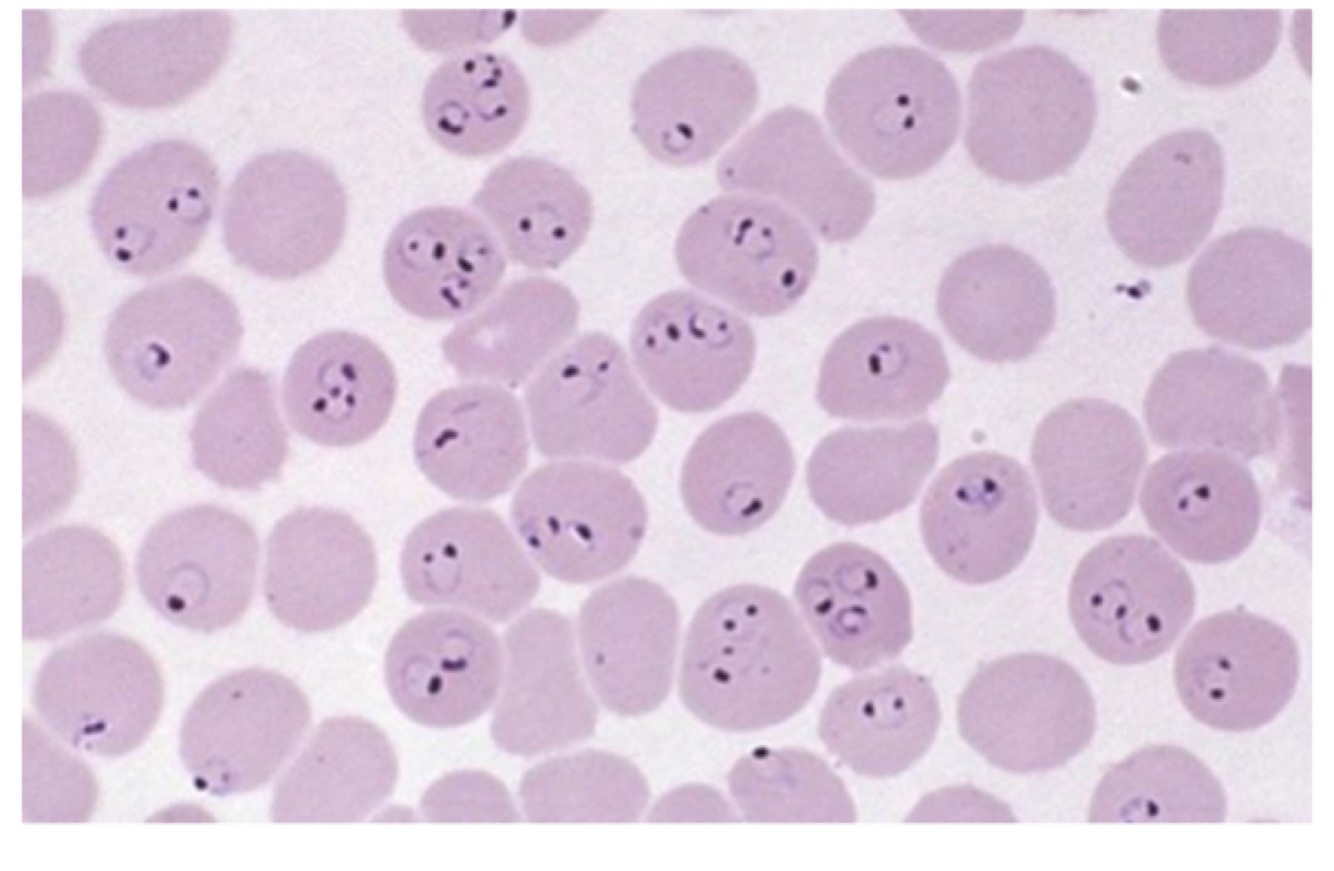

Neisseria meningitidis
Ceftriaxone (only in meningococcal sepsis)
Beta lactams - Penicillin V

Escherichia coli
Trimethoprim

Staphylococcus aureus
Flucloxacillin (for cellulitis)
Vancomycin (MRSA)

Staphylococcus epidermidis
Flucloxacillin
Streptococcus pyogenes
Penicillin V

Clostridium difficile
Metronidazole (mild cases)
Vancomycin (serious cases)

Streptococcus pneumoniae
Mild: Amoxicillin
Moderate: Amoxicillin and Doxycycline
Severe: Co-amoxiclav (IV) and Doxycycline

Viridans streptococci
Surgical antibiotic prophylaxis
Penicillin V
Gentamicin

Haemophilus influenzae
Amoxicillin

Salmonella typhi
3rd generation cephalosporins
Ceftriaxone

Legionella pneumophila
Clarythromycin

Epstein-Barr virus
Acyclovir
Varicella zoster
Acyclovir
Viral replication inhibitor

Hepatitis B
Life long antivirals to suppress viral replication
Vaccine - HbsAb

Hepatitis C
Ribovarin and interferon for 8-12 weeks
No vaccine

HIV
HAART
2 x Nucleoside inhibitors (reverse transcriptase inhibitors) and
1 x non-nucleoside reverse transcriptase inhibitor
Or
1 x protease inhibitor
Or
1 x integrase inhibitor

Adenovirus (flu/cold)
Supportive treatment

Norovirus
Supportive treatment (anti-pyretics, IV fluids)
Plasmodium falciparum - Malaria
Quinine
Doxycycline
Candida albicans
Nystatin
Clotrimazole
IV fluconazole
Systemic: amphotericin B
Aspergillous
Amphotericin B
Target chitin fungal cell wall

Cellulitis
Flucloxacillin IV
Beta lactam
Penicillin or vancomycin

Tonsillitis
Penicillin V

Sepsis
Ceftriaxone within 1 hour






